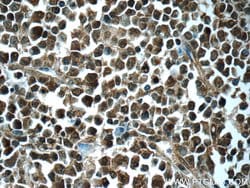
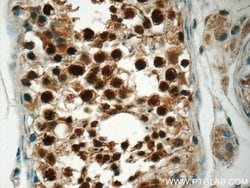
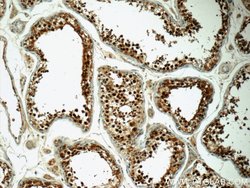

Promotional price valid on web orders only. Your contract pricing may differ. Interested in signing up for a dedicated account number?
Learn More
Learn More
CSE1L Rabbit anti-Human, Mouse, Polyclonal, Proteintech


Rabbit Polyclonal Antibody
$518.60
Specifications
| Antigen | CSE1L |
|---|---|
| Concentration | 0.19 mg/mL |
| Applications | Immunohistochemistry (Paraffin), Immunoprecipitation, Western Blot |
| Classification | Polyclonal |
| Conjugate | Unconjugated |
| Catalog Number | Mfr. No. | Quantity | Price | Quantity & Availability | |||||
|---|---|---|---|---|---|---|---|---|---|
| Catalog Number | Mfr. No. | Quantity | Price | Quantity & Availability | |||||
50-173-3778
 
|
Proteintech Group Inc
222191AP150UL |
150 μL |
Each of 1 for $518.60
|
|
|||||
Description
Proteins that carry a nuclear localization signal (NLS) are transported into the nucleus by the importin-alpha/beta heterodimer. Importin-alpha binds the NLS, while importin-beta mediates translocation through the nuclear pore complex. After translocation, RanGTP binds importin-beta and displaces importin-alpha. Importin-alpha must then be returned to the cytoplasm, leaving the NLS protein behind. The protein encoded by this gene binds strongly to NLS-free importin-alpha, and this binding is released in the cytoplasm by the combined action of RANBP1 and RANGAP1. In addition, the encoded protein may play a role both in apoptosis and in cell proliferation.Specifications
| CSE1L | |
| Immunohistochemistry (Paraffin), Immunoprecipitation, Western Blot | |
| Unconjugated | |
| Rabbit | |
| Human, Mouse | |
| P55060, Q9ERK4 | |
| 110750, 1434 | |
| CSE1L Fusion Protein Ag17556 | |
| Primary | |
| -20°C | |
| CSE1L |
| 0.19 mg/mL | |
| Polyclonal | |
| Liquid | |
| RUO | |
| PBS with 50% glycerol and 0.02% sodium azide; pH 7.3 | |
| CAS, CSE1, CSE1L, Exp2, Exportin 2, Importin alpha re exporter, XPO2 | |
| Cse1l | |
| IgG | |
| Antigen Affinity Chromatography | |
| Antibody |
Spot an opportunity for improvement?Share a Content Correction
Product Content Correction
The Fisher Scientific Encompass Program offers items which are not part of our distribution portfolio. These products typically do not have pictures or detailed descriptions. However, we are committed to improving your shopping experience. Please use the form below to provide feedback related to the content on this product.
Product Title